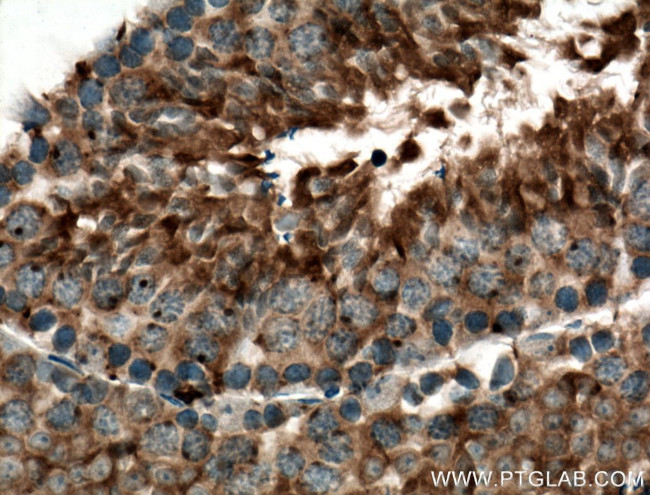
DNAJB7 Antibody in Immunohistochemistry (Paraffin) (IHC (P))

Search
Proteintech
DNAJB7 Polyclonal Antibody
{{$productOrderCtrl.translations['antibody.pdp.commerceCard.promotion.promotions']}}
{{$productOrderCtrl.translations['antibody.pdp.commerceCard.promotion.viewpromo']}}
{{$productOrderCtrl.translations['antibody.pdp.commerceCard.promotion.promocode']}}: {{promo.promoCode}} {{promo.promoTitle}} {{promo.promoDescription}}. {{$productOrderCtrl.translations['antibody.pdp.commerceCard.promotion.learnmore']}}
产品信息
18540-1-AP
种属反应
宿主/亚型
分类
类型
抗原
偶联物
形式
浓度
规格
纯化类型
保存液
内含物
保存条件
运输条件
产品详细信息
Immunogen sequence: MVDYYEVLG LQRYASPEDI KKAYHKVALK WHPDKNPENK EEAERKFKEV AEAYEVLSND EKRDIYDKYG TEGLNGGGSH FDDECEYGFT FHKPDDVFKE IFHERDPFSF HFFEDSLEDL LNRPGSSYGN RNRDAGYFFS TASEYPIFEK FSSYDTGYTS QGSLGHEGLT SFSSLAFDNS GMDNYISVTT SDKIVNGRNI NTKKIIESDQ EREAEDNGEL TFFLVNSVAN EEGFAKECSW RTQSFNNYSP NSHSSKHVSQ YTFVDNDEGG ISWVTSNRDP PIFSAGVKEG GKRKKKKRKE VQKKSTKRNC (1-309 aa encoded by BC112135)
靶标信息
DNAJB7 belongs to the evolutionarily conserved DNAJ/HSP40 family of proteins, which regulate molecular chaperone activity by stimulating ATPase activity. DNAJ proteins may have up to 3 distinct domains: a conserved 70-amino acid J domain, usually at the N terminus; a glycine/phenylalanine (G/F)-rich region; and a cysteine-rich domain containing 4 motifs resembling a zinc finger domain (Ohtsuka and Hata, 2000 ).
仅用于科研。不用于诊断过程。未经明确授权不得转售。
生物信息学
蛋白别名: dJ408N23.2; DnaJ (Hsp40) homolog, subfamily B, member 7; DnaJ homolog subfamily B member 7; dnaJ-like 5; mDj5; novel DnaJ domain protein; similar to murine protein Mrj
基因别名: 4933424H20Rik; DJ5; DNAJB7; HSC3; mDj5
UniProt ID: (Human) Q7Z6W7, (Mouse) Q9QYI8
Entrez Gene ID: (Human) 150353, (Rat) 685839, (Mouse) 57755